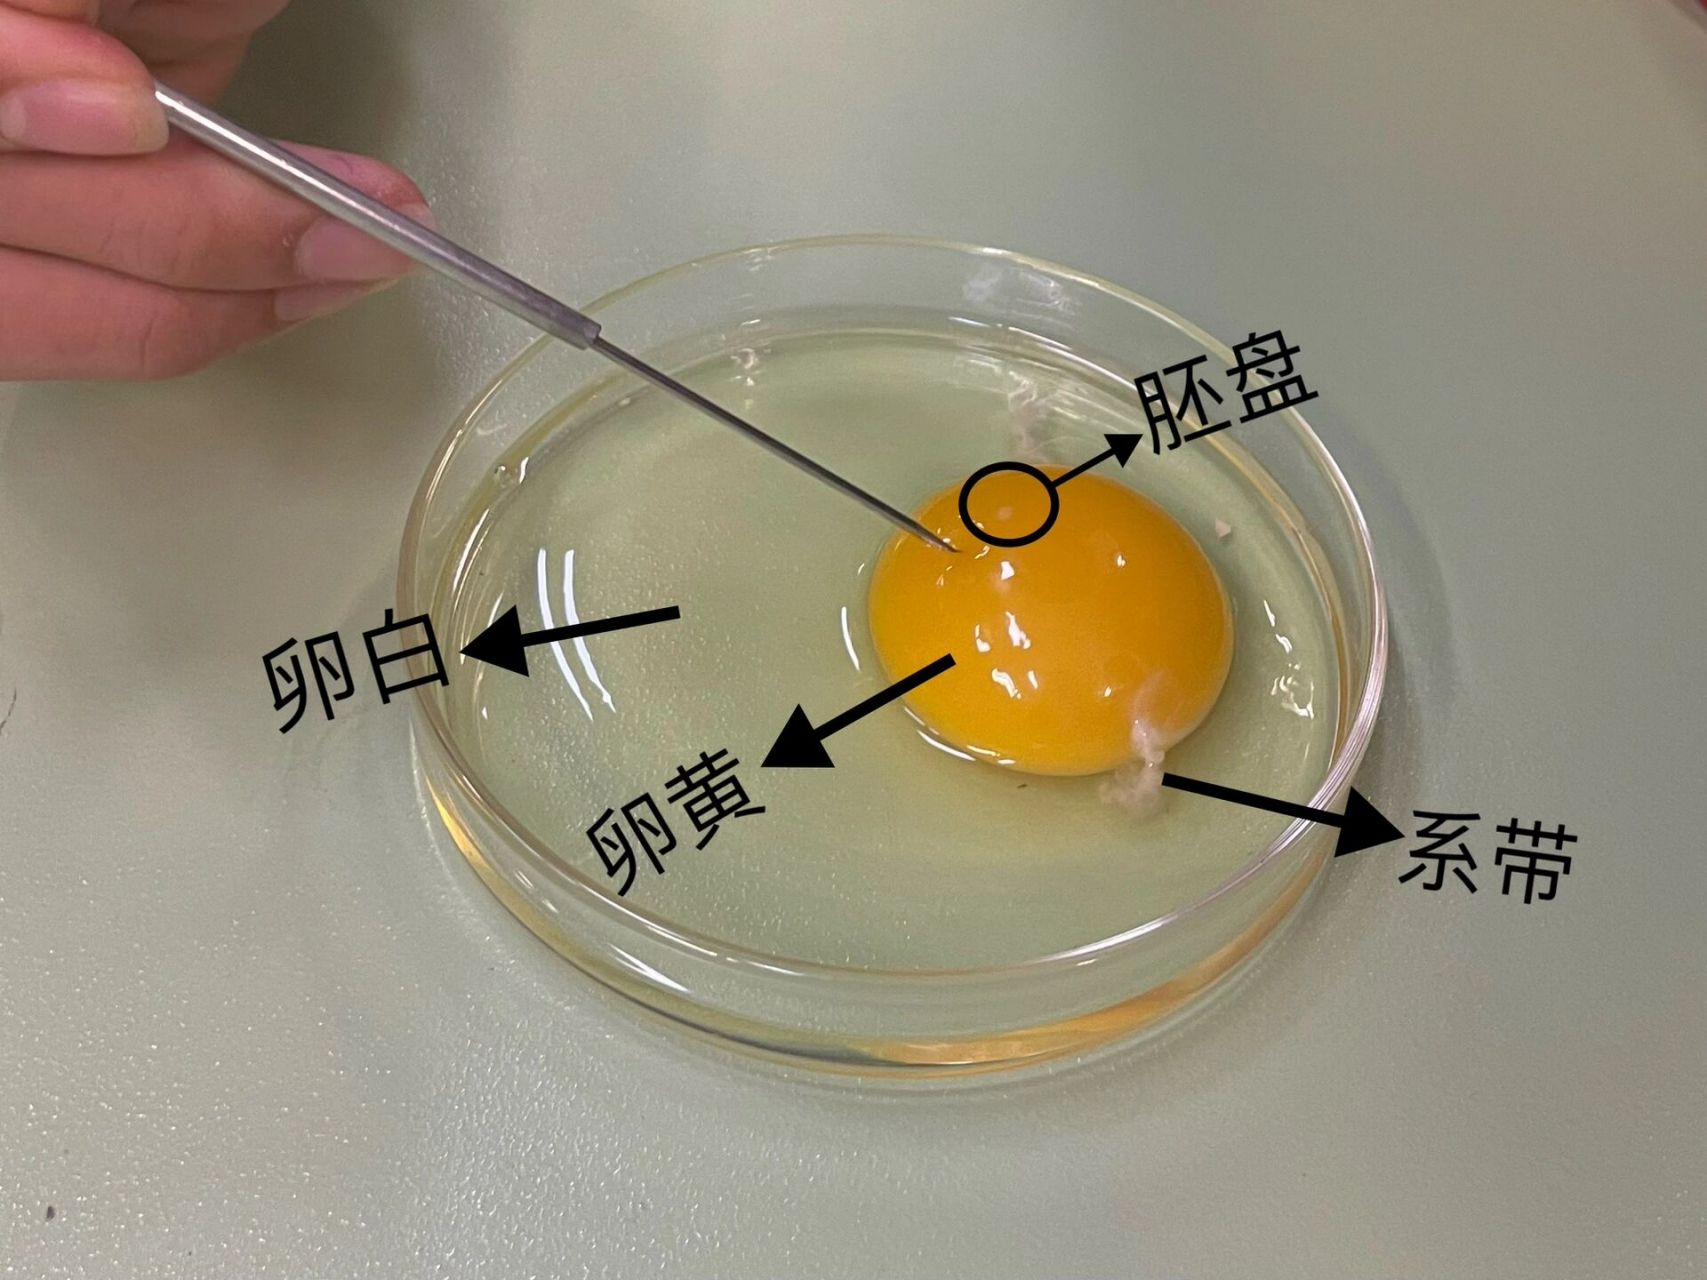
观察98鸟卵的结构 取材:鸡蛋04

鸡蛋的结构

种蛋结构及其稳定性.种蛋的稳定性和蛋液的粘稠度,系带的韧性, - 抖音
图片尺寸1440x2772
科普鸡蛋构成 - 抖音
图片尺寸1440x1920
鸡蛋的结构
图片尺寸640x722
图2鸡蛋内部结构研究蛋壳质量必须从蛋壳结构入手.
图片尺寸1080x695
理论上只要是鸡蛋,都可以孵化出小鸡的,因为诞生双黄蛋的母鸡带有一定
图片尺寸768x594
观察98鸟卵的结构 取材:鸡蛋04
图片尺寸1707x1280
鸡蛋内部结构图
图片尺寸640x480
检验一颗好鸡蛋的最高标准
图片尺寸1080x742
就会磕出来一个"标准蛋形",能看到被膜包裹的完整鸡蛋结构
图片尺寸973x731
蛋的结构
图片尺寸500x375
看了鸡蛋的形成过程图,那鸡蛋的结构你又知道多少呢?
图片尺寸554x311
初二五班崔桐赫鸡蛋的结构.pptx
图片尺寸1536x864
同样是家禽的蛋,为何鸡蛋成为了我们主要的食用蛋,而不是鸭蛋?
图片尺寸640x312
关于鸡蛋蛋壳质量不好的问题我有些话要说
图片尺寸1067x627
蛋的结构 气室 蛋清 蛋壳 蛋黄 内膜 系带
图片尺寸1080x810
鸡蛋的卵黄上还有一个白色的点,这是胚盘.
图片尺寸660x373
part1明明白白认识蛋03鸡蛋结构功能知多少【蛋黄】约占鸡蛋可食用
图片尺寸1280x979
除了我们熟知的蛋壳,蛋清,蛋黄三个大部分以外,鸡蛋中还有系带,气室
图片尺寸817x717
04鸡蛋的结构04鸡蛋的营养价值04鸡蛋能吃几个04蛋黄要去掉吗
图片尺寸690x920
好看又有营养的煮鸡蛋其实是泡出来的你相信吗
图片尺寸529x363